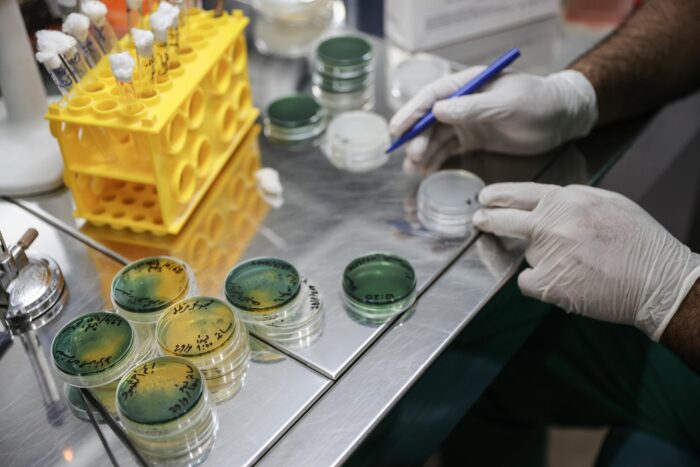

Es gibt wieder mehr Ausbrüche von Cholera-Erkrankungen. Das teilte die Weltgesundheitsorganisation mit. Die Entwicklung sei besorgniserregend, heißt es.
WHO besorgt über weltweit steigende Zahl von Cholerafällen
Die Zahl der Cholera-Ausbrüche ist in diesem Jahr weltweit gestiegen. In den ersten neun Monaten hätten 27 Länder Ausbrüche gemeldet, berichtete der Chef der Weltgesundheitsorganisation (WHO), Tedros Adhanom Ghebreyesus, am Mittwoch in Genf. Allein aus Syrien seien in den vergangenen Wochen mehr als 10.000 Fälle gemeldet worden. Aus Haiti seien gerade zwei Fälle gemeldet worden, nachdem das Land drei Jahre Cholera-frei war. Die wahre Zahl liege dort wahrscheinlich deutlich höher.
Die WHO nannte keine weltweiten Fallzahlen. Die Europäische Gesundheitsbehörde (ECDC) berichtete Mitte September von knapp 40.000 neu gemeldeten Fällen innerhalb eines Monats. Die WHO rechnet mit einer hohen Dunkelziffer, weil aus vielen Regionen keine verlässlichen Zahlen vorliegen.
Die Entwicklung sei besorgniserregend, sagte Tedros. Es gebe nicht nur mehr Ausbrüche, sondern es kämen dabei auch mehr Menschen um. Die Todesrate sei in diesem Jahr fast dreimal so hoch wie im Durchschnitt der vergangenen fünf Jahre. Cholera breite sich aus, wo Armut und Konflikte herrschten und Menschen mit den Folgen des Klimawandels zu kämpfen hätten, sagte Tedros.
Cholera ist eine durch Bakterien ausgelöste Durchfallerkrankung, die zu schwerem Flüssigkeitsverlust führt. Die Ansteckung erfolgt meist durch Trinkwasser, das mit Fäkalien oder Erbrochenem von Kranken verseucht ist. Ohne medizinische Versorgung können Menschen innerhalb weniger Stunden sterben. Bei Flüssigkeitszufuhr ist die Überlebenschance groß. «Die Realität ist aber, dass viele Menschen keinen Zugang zu so simplen Interventionen haben», sagte Tedros.
Die WHO habe 2013 ein Notlager für Cholera-Impfstoffe eingerichtet. Das Material reiche aber nicht. «Wir rufen die führenden Impfstoffhersteller auf, mit uns darüber zu sprechen, wie wir die Impfstoffproduktion ankurbeln können», so Tedros.









